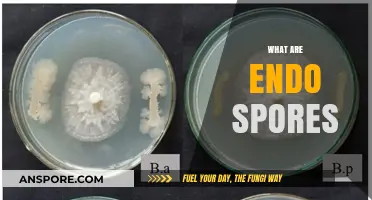
Understanding Endospores: Nature's Ultimate Survival Mechanism Explained

Spores are reproductive structures produced by various organisms, including plants, fungi, algae, and some bacteria, that enable them to survive harsh conditions and disperse to new environments. Examples of spores include fungal spores, such as those from mushrooms and molds, which are lightweight and easily carried by wind or water to colonize new areas. Plant spores, like those from ferns and mosses, are crucial for their life cycles, allowing them to reproduce asexually in environments where seeds are not feasible. Bacterial endospores, produced by certain bacteria like *Clostridium* and *Bacillus*, are highly resistant to extreme temperatures, radiation, and chemicals, ensuring survival in adverse conditions. Algal spores, such as those from seaweed and phytoplankton, facilitate their spread across aquatic ecosystems. These diverse examples highlight the adaptability and resilience of spores as a survival and dispersal mechanism across different biological kingdoms.
| Characteristics | Values |
|---|---|
| Definition | Spores are reproductive structures, often single-celled, produced by bacteria, fungi, plants, and some protozoa. They are designed for dispersal and survival in unfavorable conditions. |
| Types | Bacterial Spores: Endospores (e.g., Bacillus, Clostridium). Fungal Spores: Conidia (e.g., Aspergillus), Sporangiospores (e.g., Mucor), Zygospores (e.g., Rhizopus), Ascospores (e.g., Saccharomyces), Basidiospores (e.g., Mushrooms). Plant Spores: Sporopollenin-coated spores (e.g., ferns, mosses, liverworts). Protozoan Spores: Oocysts (e.g., Cryptosporidium). |
| Function | Dispersal, survival in harsh environments (heat, desiccation, chemicals), and reproduction. |
| Structure | Typically single-celled, often with a protective outer layer (e.g., sporopollenin in plant spores, exosporium in bacterial spores). |
| Size | Varies widely: Bacterial spores (~1 μm), fungal spores (1–100 μm), plant spores (10–200 μm). |
| Dormancy | Can remain dormant for extended periods (years to millennia) until favorable conditions return. |
| Dispersal | Wind, water, animals, or mechanical means (e.g., bursting sporangia in fungi). |
| Germination | Activates under suitable conditions (moisture, temperature, nutrients) to form a new organism. |
| Resistance | Highly resistant to extreme conditions, including UV radiation, heat, and chemicals. |
| Ecological Role | Key in the life cycles of many organisms, contributing to biodiversity and ecosystem resilience. |
What You'll Learn
- Fungal Spores: Examples include Penicillium, Aspergillus, and mushrooms, aiding in reproduction and dispersal
- Bacterial Spores: Bacillus and Clostridium form spores for survival in harsh conditions
- Plant Spores: Ferns, mosses, and algae produce spores for asexual reproduction and spread
- Protozoan Spores: Parasites like Plasmodium release spores (oocysts) for transmission and infection
- Seed Plant Spores: Gymnosperms and angiosperms use pollen grains as microspores for reproduction

Fungal Spores: Examples include Penicillium, Aspergillus, and mushrooms, aiding in reproduction and dispersal
Fungal spores are nature’s ingenious solution for survival and propagation, and examples like *Penicillium*, *Aspergillus*, and mushrooms illustrate their diversity and function. These microscopic structures are not merely reproductive units; they are also agents of dispersal, allowing fungi to colonize new environments with remarkable efficiency. Consider *Penicillium*, the genus behind penicillin, whose spores are lightweight and easily airborne, enabling them to travel vast distances. Similarly, *Aspergillus* spores thrive in diverse habitats, from soil to food, showcasing their adaptability. Mushrooms, though more visible, rely on spores released from their gills to ensure the next generation. Together, these examples highlight the dual role of fungal spores: as both reproductive tools and dispersal mechanisms.
Analyzing the mechanics of spore dispersal reveals a fascinating interplay of biology and physics. *Penicillium* spores, for instance, are ejected from their conidiophores with enough force to become airborne, yet they are small enough (typically 2–5 microns) to remain suspended in air currents for hours. This design maximizes their reach, increasing the likelihood of landing in a suitable environment. *Aspergillus* spores, on the other hand, are often dispersed by wind or water, with some species producing up to 10,000 spores per structure. Mushrooms employ a different strategy, releasing trillions of spores in a single flush, ensuring at least a few find fertile ground. Understanding these mechanisms not only sheds light on fungal ecology but also informs strategies for controlling spore-related issues, such as mold in homes or food spoilage.
For those interested in practical applications, managing fungal spores requires a combination of vigilance and targeted action. In indoor environments, maintaining humidity below 60% discourages *Aspergillus* and *Penicillium* growth, as these fungi thrive in damp conditions. HEPA filters can capture airborne spores, reducing their spread. In food storage, proper ventilation and temperature control (below 4°C for perishables) inhibit spore germination. For mushroom cultivation, controlling light and moisture levels during fruiting encourages optimal spore release. Notably, while some spores are harmless, others can cause allergies or infections, particularly in immunocompromised individuals. Awareness of these risks underscores the importance of spore management in both personal and industrial settings.
Comparing fungal spores to other reproductive structures, such as plant seeds, reveals both similarities and unique adaptations. Unlike seeds, which often require animals or water for dispersal, fungal spores are self-dispersing, relying on wind, water, or even insects for transport. Their size and structure—often single-celled and protected by a resilient cell wall—allow them to survive harsh conditions, from extreme temperatures to UV radiation. This resilience is particularly evident in *Aspergillus* spores, which can remain dormant for years before germinating under favorable conditions. Mushrooms, meanwhile, produce spores in such vast quantities that their strategy resembles a biological lottery, ensuring at least some offspring succeed. These adaptations make fungal spores not just examples of reproductive efficiency but also models of evolutionary ingenuity.
In conclusion, fungal spores from *Penicillium*, *Aspergillus*, and mushrooms exemplify the remarkable ways fungi ensure their survival and proliferation. Their role in reproduction and dispersal is not just a biological curiosity but a practical concern with implications for health, agriculture, and industry. By understanding their mechanisms and managing their presence, we can harness their benefits while mitigating their risks. Whether you’re a homeowner combating mold, a farmer cultivating mushrooms, or a scientist studying fungal ecology, the study of fungal spores offers invaluable insights into the natural world and our place within it.
Launching Spore on Mac: A Step-by-Step Beginner's Guide
You may want to see also

Bacterial Spores: Bacillus and Clostridium form spores for survival in harsh conditions
Bacterial spores are nature's ultimate survival capsules, and among the most resilient are those formed by *Bacillus* and *Clostridium*. These spore-forming bacteria have mastered the art of enduring extreme conditions—heat, desiccation, radiation, and chemicals—that would destroy most other life forms. Unlike vegetative cells, spores are dormant, metabolically inactive structures encased in a protective layer, allowing them to persist for years, even centuries, until conditions improve. This ability makes them both fascinating and formidable, particularly in contexts like food preservation, healthcare, and environmental science.
Consider the *Bacillus* genus, which includes species like *Bacillus anthracis* (the causative agent of anthrax) and *Bacillus cereus* (a common food contaminant). When nutrients become scarce or conditions turn hostile, these bacteria initiate sporulation, a complex process involving the formation of a thick, multi-layered spore coat and a cortex rich in peptidoglycan. The resulting spore can withstand boiling temperatures for extended periods, a trait that poses significant challenges in food processing. For instance, *Bacillus* spores in canned foods can survive pasteurization (typically 72°C for 15 seconds), necessitating more aggressive sterilization methods like retorting at 121°C for 15–30 minutes. Practical tip: Always follow proper canning guidelines, including using a pressure canner for low-acid foods, to eliminate these resilient spores.
Clostridium spores, on the other hand, are notorious for their role in diseases like botulism and tetanus. Clostridium botulinum, for example, produces spores that can germinate in the anaerobic conditions of improperly preserved foods, leading to toxin production and severe illness. A single dose of botulinum toxin as small as 1 nanogram per kilogram of body weight can be fatal, making prevention critical. Unlike Bacillus, Clostridium spores often require specific triggers, such as the absence of oxygen and certain nutrients, to initiate germination. This distinction highlights the importance of understanding spore behavior in different environments. Caution: Always refrigerate oils infused with garlic or herbs, as these conditions can support Clostridium spore growth.
Comparing *Bacillus* and *Clostridium* spores reveals both similarities and differences in their survival strategies. Both rely on a robust spore structure, but *Bacillus* spores are more heat-resistant, while *Clostridium* spores are more sensitive to oxygen. This comparison underscores the need for tailored approaches to control them. For instance, while boiling may suffice to kill vegetative cells, it often fails to eliminate spores, particularly those of *Bacillus*. Takeaway: Effective spore management requires a combination of heat, chemicals, and environmental control, tailored to the specific bacterium in question.
In practical terms, understanding bacterial spores is essential for industries ranging from food production to healthcare. For example, hospitals use autoclaves operating at 121°C and 15 psi for 15–30 minutes to sterilize surgical instruments, ensuring *Bacillus* and *Clostridium* spores are destroyed. Similarly, food manufacturers employ hurdle technology—combining heat, pH adjustments, and preservatives—to prevent spore germination and toxin production. Age-specific advice: Infants under 12 months should avoid honey due to the risk of *Clostridium botulinum* spores, which their immature gut microbiomes cannot handle. By recognizing the unique traits of these spores, we can implement strategies that safeguard health and extend the shelf life of products.
Unveiling the Chromosome Count in Flower Spores: A Botanical Insight
You may want to see also

Plant Spores: Ferns, mosses, and algae produce spores for asexual reproduction and spread
Ferns, mosses, and algae rely on spores as their primary method of asexual reproduction and dispersal, a strategy that has ensured their survival across diverse ecosystems for millions of years. Unlike seeds, spores are single-celled and lack the stored nutrients or protective layers, making them lightweight and easily carried by wind, water, or animals. This simplicity allows these plants to colonize new habitats efficiently, even in challenging environments where flowering plants might struggle. For instance, fern spores can travel miles before landing on a suitable surface, while moss spores often settle in the nooks of trees or rocks, forming new colonies.
To understand the practicality of spore production, consider the life cycle of a fern. After a spore germinates, it grows into a small, heart-shaped gametophyte, which is often overlooked due to its size. This gametophyte produces eggs and sperm, which, when fertilized, develop into the familiar fern plant. The process is entirely asexual until fertilization, highlighting the spore’s role as a self-sufficient reproductive unit. Gardeners cultivating ferns often collect spores from the undersides of mature fronds, sprinkle them on moist soil, and maintain humidity to encourage growth—a technique that mimics nature’s dispersal methods.
Mosses take spore production a step further by developing specialized structures called sporangia, typically located on a slender stalk called a seta. These sporangia release spores in vast quantities, ensuring at least some find favorable conditions. In urban environments, moss spores often colonize cracks in sidewalks or rooftops, demonstrating their adaptability. For enthusiasts looking to grow moss, collecting spores from healthy patches and spreading them on damp, shaded surfaces can yield lush green carpets within months. Patience is key, as moss growth is slow but steady.
Algae, though often aquatic, also produce spores as part of their life cycle. Certain species, like *Chara*, release spores that can survive desiccation, allowing them to persist in dry conditions until water returns. This resilience makes algae spores ideal for studying extremophile organisms. Researchers often isolate algae spores from soil or water samples, cultivate them in controlled environments, and analyze their genetic makeup to understand their survival mechanisms. For hobbyists, observing algae spores under a microscope reveals their intricate structures, offering a glimpse into the microscopic world of plant reproduction.
In comparison to other reproductive methods, spores offer a unique advantage: they require no pollinators or partners, making them self-reliant. However, this independence comes with a trade-off—spores are vulnerable to harsh conditions and rely on sheer numbers for success. For example, a single fern can release thousands of spores, yet only a fraction may develop into mature plants. This strategy, while inefficient, ensures that ferns, mosses, and algae continue to thrive in diverse habitats, from tropical rainforests to Arctic tundras. By studying these plants, we gain insights into the adaptability and resilience of life on Earth.
Are Laccaria Spores White? Unveiling the Truth About Their Color
You may want to see also

Protozoan Spores: Parasites like Plasmodium release spores (oocysts) for transmission and infection
Protozoan spores, particularly those released by parasites like *Plasmodium*, play a critical role in the transmission and perpetuation of infections. Unlike the dormant, resilient spores of fungi or plants, protozoan spores—known as oocysts—are specialized structures designed for dispersal and invasion of new hosts. These oocysts are not merely survival mechanisms but active agents of disease spread, encapsulating the parasite’s next generation in a protective shell until environmental conditions trigger their release. Understanding this process is essential for disrupting the life cycle of parasites like *Plasmodium*, the causative agent of malaria, which claims over 600,000 lives annually, primarily in children under five in sub-Saharan Africa.
The lifecycle of *Plasmodium* exemplifies the strategic use of spores in parasitic transmission. After a female *Anopheles* mosquito ingests blood from an infected host, the parasite’s gametocytes fuse within the mosquito’s gut, forming a zygote that develops into an ookinete. This ookinete penetrates the gut wall and matures into an oocyst, where thousands of sporozoites are produced. Once the oocyst ruptures, these sporozoites migrate to the mosquito’s salivary glands, ready to infect a new human host during the next bite. This process highlights the oocyst’s dual role: as a protective incubator and a dispersal mechanism. For instance, a single *Anopheles* mosquito can carry up to 10,000 sporozoites, making each bite a potential vector for infection.
Preventing the release and transmission of these spores is a cornerstone of malaria control strategies. Insecticide-treated bed nets, for example, reduce mosquito bites by up to 50%, while indoor residual spraying targets mosquitoes before they can transmit sporozoites. Antimalarial drugs like chloroquine and artemisinin-based combination therapies (ACTs) are administered to infected individuals to kill parasites in the blood, preventing gametocyte formation and subsequent oocyst development in mosquitoes. However, drug resistance—such as *Plasmodium falciparum*’s resistance to chloroquine—underscores the need for innovative approaches, including vaccines like RTS,S, which targets the sporozoite stage to prevent liver infection.
Comparatively, protozoan spores differ from fungal or bacterial spores in their function and structure. While fungal spores are primarily for survival in harsh conditions, protozoan oocysts are transient, existing solely to bridge the gap between hosts. Their walls are thinner and more fragile, optimized for rapid development rather than long-term endurance. This distinction is crucial for developing targeted interventions. For instance, disrupting oocyst formation in mosquitoes through genetic modification or blocking sporozoite invasion of liver cells could halt malaria transmission more effectively than broad-spectrum antifungals or antibiotics.
In practical terms, individuals in endemic areas can minimize exposure by using long-lasting insecticidal nets (LLINs) and wearing permethrin-treated clothing. Travelers should take prophylactic medications like mefloquine or doxycycline, starting 1–2 weeks before entering high-risk zones and continuing for 4 weeks after departure. Early diagnosis and treatment are equally vital; rapid diagnostic tests (RDTs) can detect *Plasmodium* antigens within 15 minutes, enabling prompt administration of ACTs. By targeting the spore-driven lifecycle of parasites like *Plasmodium*, we can reduce transmission, save lives, and move closer to global malaria eradication.
Step-by-Step Guide to Creating Your Spore Account Easily
You may want to see also

Seed Plant Spores: Gymnosperms and angiosperms use pollen grains as microspores for reproduction
Pollen grains, often overlooked as mere allergens, are the microscopic heroes of seed plant reproduction. In both gymnosperms (like pines and spruces) and angiosperms (flowering plants), these tiny structures function as microspores, carrying the male genetic material necessary for fertilization. Each pollen grain is a marvel of efficiency, encased in a protective outer layer that withstands environmental stresses, from wind to rain, ensuring it reaches its destination—the female reproductive organ. This process, known as pollination, is the first step in creating seeds, the lifeblood of future generations of plants.
Consider the journey of a pollen grain in a pine tree, a classic gymnosperm. Produced in vast quantities within male cones, these microspores are released into the wind, a strategy known as anemophily. Once airborne, they travel until they land on the exposed ovules of a female cone. Here, the pollen grain germinates, forming a pollen tube that delivers sperm cells to the egg. This method, while inefficient due to the reliance on wind, ensures widespread dispersal, a critical advantage in diverse ecosystems. For gardeners or foresters, understanding this process highlights the importance of windbreaks and spacing in pine plantations to optimize pollination.
Angiosperms, on the other hand, often employ more targeted strategies. Take the example of an apple tree, where pollen grains are produced in the anthers of flowers. Unlike gymnosperms, angiosperms frequently rely on animals, particularly insects, for pollination. Bees, butterflies, and even birds are drawn to flowers by color, scent, and nectar, inadvertently transferring pollen as they feed. This co-evolutionary relationship is so precise that some plants, like orchids, have developed specialized structures to ensure pollen adheres to specific body parts of their pollinators. For home gardeners, planting bee-friendly flowers like lavender or borage near fruit trees can significantly enhance pollination rates, leading to larger, healthier yields.
The structure of pollen grains themselves is a testament to their function. In angiosperms, the outer exine layer is often sculpted with intricate patterns, visible only under a microscope, which aid in species identification and ensure compatibility during pollination. Gymnosperm pollen, while less ornate, is equally specialized, with air sacs that enhance wind dispersal. These adaptations underscore the precision of nature’s design, where form follows function. For educators or hobbyists, examining pollen grains under a microscope can provide a fascinating glimpse into the diversity of plant reproductive strategies.
Finally, the role of pollen grains in seed production cannot be overstated. Without successful pollination, plants cannot produce seeds, disrupting food chains and ecosystems. For farmers, this means monitoring pollen viability and ensuring optimal conditions for pollinators. For conservationists, protecting habitats that support diverse pollinator populations is crucial. Even urban dwellers can contribute by creating pollinator-friendly spaces, such as planting native flowers on balconies or in community gardens. In every case, the humble pollen grain serves as a reminder of the interconnectedness of life, a tiny yet powerful force driving the continuity of plant species.
Cubensis Spores Shelf Life: How Long Do They Remain Viable?
You may want to see also
Frequently asked questions
Examples of fungal spores include conidia (asexual spores produced by molds like *Aspergillus*), basidiospores (produced by mushrooms and other basidiomycetes), and asci (spore-containing structures in sac fungi like *Saccharomyces*).
Examples of plant spores include fern spores (reproductive units found on the undersides of fern leaves), moss spores (produced in capsules on moss plants), and pollen grains (male reproductive spores in seed plants).
Examples of bacterial spores include endospores, which are highly resistant structures produced by bacteria like *Bacillus anthracis* (causes anthrax) and *Clostridium botulinum* (causes botulism), allowing them to survive harsh conditions.